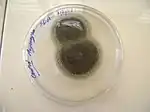

Aspergillus niger
Aspergillus niger, l'aspergille noir, est un champignon filamenteux ascomycète de l'ordre des Eurotiales. C'est une des espèces les plus communes du genre Aspergillus qui apparait sous forme d'une moisissure de couleur noire sur les fruits et légumes. Aucune forme sexuée (téléomorphe) n'est connue.
Aspergillus niger est une espèce importante sur le plan économique car elle est utilisée en fermentation industrielle pour produire de l'acide citrique et gluconique ou des enzymes. En Chine, A. niger intervient dans la fermentation de produits alimentaires comme le vin de céréale ou le thé pu'er.
Cette moisissure est un contaminant omniprésent qui est habituellement inoffensif. Mais dans des circonstances spéciales et rares, elle peut être toxique et pathogène car responsable de mycoses pulmonaires chez l'homme et les oiseaux.
Écologie

Substrats
Aspergillus niger est une moisissure très commune, préférant habituellement les sols secs et chauds. Elle a été isolée dans des substrats très variés comme[1] :
- des substrats naturels : sol, bois, cire, eau (douce, polluée, lits de rivière), légumes, fruits frais et secs, noix et noisettes, poussières atmosphériques
- des produits manufacturés : émulsion de cosmétique, plastiques, photographie, cuir, caoutchouc, composants électroniques, métaux, papiers, peinture murale ou artistique, textiles (coton, jute, laine), vernis.
A. niger est une espèce cosmopolite qui a été signalée dans le monde entier.
Cette moisissure se développe aussi bien en intérieur (où il est possible de la confondre avec Stachybotrys spp) que sous forte lumière, en extérieur. C'est une des espèces les plus communes du sol. Elle se développe sur la matière végétale en décomposition, comme les composts. Elle peut contaminer la viande et les œufs, ou les fruits séchés au soleil. Elle peut aussi endommager les cuirs en surface et en épaisseur.
Milieu
Aspergillus niger est une espèce xérophile, pouvant vivre dans un milieu assez pauvre en eau[2]. Elle peut germer[3] dans un milieu ayant une activité de l'eau de aw=0,77 à la température de 35 °C. C'est pourquoi elle est fréquemment isolée dans les fruits secs et les noix. Elle peut aussi vivre dans un environnement très humide (humidité relative de 90 à 100 %).
A. niger peut croître jusqu'à un pH de 2 (acide) à haute activité aw.
A. niger est une espèce mésophile dont les températures optimales de croissance[1] sont entre 11 et 42 °C. La température maximale est de 48 °C mais elle peut survivre à 60 °C. Les micro-ondes n'ont aucun effet sur les conidies.
Morphologie
Le développement d'Aspergillus niger n'est connu que par sa multiplication asexuée (l'anamorphe). La forme habituelle est donc celle d'un champignon filamenteux comportant des hyphes septés (filaments cloisonnés), haploïdes et ramifiés formant un mycélium.
| 'L'anamorphe dAspergillus niger | |
|---|---|
| En condition de stress[4], des organes de reproduction asexuée (ou conidiophores) se développent, à partir du mycélium. Ils sont formés d'une tige filamenteuse portant les cellules conidiogènes, produisant des spores (ou conidies). Les espèces du genre Aspergillus sont caractérisées par un conidiophore possédant une extrémité renflée (ou vésicule). Cette vésicule terminale est sphérique (de 40 µm de diamètre) et porte des cellules conidiogènes fertiles (ou phialides), en forme de bouteille[5]. Les phialides sont disposées sur tout le pourtour de la vésicule et sont portées par une cellule stérile (ou métule) directement insérée sur la vésicule. Les conidiophores sont lisses, hyalins ou brunâtres dans la partie supérieure, très longs (de 1 à 3 mm). La tête aspergillaire est globuleuse et radiée, noire à maturité. |
![]() |
Les conidies sont des spores asexuées, unicellulaires et uninucléées, globuleuses de 2 à 3 µm de diamètre, produites par les phialides. Elles sont noires ou brun foncé et ornementées d'épines et saillies (forme échinulée). Elles sont souvent disposées en chaîne et dispersées par le vent. |
![]() |
La germination d'une conidie se déroule en deux étapes :
|
![]() |
Culture
L'identification des Aspergillus se fait par une culture en boîte de Petri, sur des milieux de culture classiques[n 1]. Les aspergillus peuvent être isolés à l'aide de clés utilisant la coloration de la colonie, la pigmentation et la forme de la tête aspergillaire et l'aspect des spores.
Aspergillus niger forme des colonies atteignant 4 à 5 cm de diamètre en 7 jours sur milieu Czapek incubé à 25 °C, de couleur noire[6]. La température optimale de croissance se situe entre 25 et 30 °C mais il peut croître jusqu'à la température de 47-48 °C. La colonie est d'abord blanche et translucide puis devient noire en sporulant. Le pH du milieu reste inchangé (pH final 5,5).
Métabolisme
Les champignons sont des organismes hétérotrophes qui puisent les substances nutritives dans l'environnement, en commençant éventuellement par les digérer à l'extérieur de la cellule, puis en les ingurgitant par l'intermédiaire de protéines qui traversent la membrane plasmique (les transporteurs membranaires).
Dans son habitat naturel, les souches d'A. niger sécrètent en grandes quantités une grande variété d'enzymes nécessaires pour extraire les nutriments des substances organiques biopolymériques. Cette capacité est utilisée par l'industrie des fermentations pour produire des enzymes à prix compétitifs. Le séquençage du génome[7] a confirmé la présence d'un grand nombre de transporteurs impliqués dans le transport de nombreux substrats.
Il est aussi possible de détourner le métabolisme central de cette moisissure (consistant en un réseau de milliers de réactions, révélés par le séquençage du génome) pour produire des acides organiques. C'est ainsi que l'acide citrique, un métabolite ordinaire, produit normalement par le métabolisme énergétique de A. niger, peut être produit en grande quantité sous des conditions de déséquilibre métabolique. Suivant un modèle mathématique du métabolisme de A. niger, en doublant la concentration de certaines enzymes, on obtient une production d'acide citrique multipliée par 12 par rapport aux conditions normales[8].

La voie métabolique qui conduit du saccharose à l'acide citrique (ou citrate) peut être schématisée dans une boîte noire décomposable en cinq éléments :
1. Le processus commence à l'extérieur de la cellule fongique. Le saccharose est d'abord hydrolysé en glucose et fructose par une enzyme invertase fixée sur la membrane. L'induction de la synthèse d'invertase est produite par des substrats riches en ß-fructofuranoside comme le saccharose, le raffinose et le turanose ainsi que l'inuline[10]. À l'inverse, la présence de glucose et fructose réprime la synthèse d'invertase.
2. Puis les deux hexoses (glucose, fructose) produits sont transportés à l'intérieur de la cellule par des protéines de transport membranaires.
3. Glycolyse : le glucose entre dans la voie métabolique de récupération de l'énergie sous forme d'ATP (sans nécessiter d'oxygène). L'oxydation d'une mole de glucose donne deux moles de pyruvate.
4. L'étape suivante se passe dans le cycle de l'acide citrique (ou cycle des acides tricarboxyliques) à l'intérieur de la mitochondrie. Le pyruvate pénètre dans la mitochondrie puis rentre dans le cycle de l'acide citrique par plusieurs voies. Le pyruvate (avec l'acétylCoA) fait partie des métabolites ayant la plus grande connectivité, puisqu'il est impliqué dans 57 réactions[11].
5. Excrétion de l'acide citrique de la mitochondrie et du cytosol.
Le séquençage de l'ADN permet une reconstruction du réseau métabolique (Sun et als[11], Andersen et als[9]) de Aspergillus niger impliquant pour Sun et als 2 443 réactions et 2 349 métabolites. Des connexions innombrables relient les intermédiaires de la glycolyse, du cycle des acides tricarboxyliques, et les 146 métabolites d'autres voies métaboliques.
Les progrès du séquençage génétique et de la bio-informatique, permettent de comprendre de mieux en mieux le contenu de la boîte noire, sans en avoir encore élucidé complètement toutes les particularités.
Utilisations
Utilisations traditionnelles
L'activité enzymatique des moisissures a été traditionnellement utilisée en Asie orientale pour fermenter les céréales, le soja ou les feuilles de thé pour donner respectivement du vin de céréale, de la sauce de soja et du pu-erh.
Depuis l'antiquité, les Chinois produisent un vin de céréale huangjiu (黄酒) en inoculant des grains de millet ou de riz glutineux cuits à la vapeur avec un ferment qu 曲, capable de produire simultanément une saccharification et une fermentation alcoolique. C'est par cette technique introduite au Japon, que le saké est aussi produit. On sait maintenant depuis le milieu du XXe siècle que les ferments qu (ou koji en japonais) sont constitués d'un cocktail de moisissures[12] (Aspergillus oryzae, A. niger etc. ; Rhizopus spp. etc., Mucor spp., Penicillium etc), de levures (Saccharomyces cerevisiae, Pichia etc.) et de bactéries (Bacillus subtilis, Acetobacter, Lactobacillus etc.). Les moisissures produisent des amylases en abondance qui hydrolysent l'amidon des céréales en sucres simples (qui pourront ensuite être fermentés en alcool par les levures).
Le thé pu'er est actuellement produit comme un thé vert, c'est-à-dire que les feuilles sont légèrement torréfiées, roulées et séchées au soleil. Elles sont ensuite mises en tas pour subir une fermentation en milieu humide. Le micro-organisme le plus commun chez les producteurs de pu'er et qui joue le rôle majeur dans la fermentation est A. niger[13].
Utilisations modernes
Dès 1917, le chimiste américain J. Currie[14] avait montré que certaines souches de A. niger pouvaient excréter de grandes quantités d'acide citrique, à condition d'être cultivées sur un milieu nutritif très riche en sucre, additionné de sels minéraux et à un pH initial de 2,5-3,5. Ces études furent à la base de la production industrielle de l'acide citrique qui commença aux États-Unis en 1923 puis se poursuivit dans les années 1930 en Angleterre, Allemagne et Union Soviétique.
Actuellement, A. niger est utilisé pour la production d'acides organiques, d'enzymes et de protéines hétérologues. C'est un micro-organisme de choix en raison de sa stabilité génétique, de ses rendements élevés, de son aptitude à fermenter une variété de substrats bon marché et de l'absence de métabolites produits qui seraient indésirables[15].
Les principaux métabolites d'Aspergillus niger ayant une grande valeur économique pour l'industrie agro-alimentaire sont la production d'acides organiques et d'enzymes.
Production d'acides organiques
Le métabolisme fermentaire « aérobie » d'Aspergillus niger est utilisé pour produire de l'acide citrique, gluconique, oxalique et fumarique.
L'acide citrique est l'ingrédient principal des sodas. L'industrie agroalimentaire l'utilise comme acidifiant et antioxydant pour renforcer les saveurs et conserver les jus de fruits, les glaces et les confitures. Il présente une activité bactéricide et bactériostatique contre Listeria monocytogenes, un pathogène d'origine alimentaire. Son activité antioxydante est aussi utilisée dans les industries pharmaceutique et chimique. Il est autorisé en Europe (sous l'étiquette E330) comme additif alimentaire.
Actuellement, l'acide citrique est produit en fermenteur (bioréacteur) avec un substrat riche en glucide ensemencé par A. niger. Cette technique assure une production de masse de l'acide citrique, à un prix de revient très inférieur à celui de l'ancien procédé d'extraction à partir des citrons. Environ 99 % de la production mondiale d'acide citrique se fait par fermentation microbienne sur culture de surface ou submergée[16] et récemment par la fermentation en milieu solide.
L'accumulation de l'acide citrique est fortement influencée par la composition du milieu de fermentation[14]. Certains nutriments doivent être en excès (le sucre, les protons et l'oxygène) d'autres doivent être en quantités restreintes (l'azote, le phosphate). La concentration du sucre en solution se situe en général entre 15 et 25 %.
Il est estimé qu'environ 80 % de la production mondiale d'acide citrique[15] est obtenue par fermentation en submersion d'une culture de A. niger dans un milieu contenant du glucose ou du saccharose - principalement un sirop fait des mélasses de betteraves sucrières ou de cannes à sucre provenant de l'industrie sucrière. La fermentation est le plus souvent effectuée en bioréacteurs avec un mode d'alimentation discontinu, dit par batch.
La technologie la plus ancienne est la « fermentation en surface ». La moisissure développe un tapis mycélien sur la surface du milieu. La fermentation produit un fort dégagement de chaleur qui doit être évacuée par un système d'aération puissant. Ce procédé n'est plus utilisé que dans de petites ou moyennes entreprises[15].
Depuis quelques années[Quand ?], la production d'acide citrique par une troisième technique de fermentation a fait l'objet d'un intérêt croissant. Il s'agit de la fermentation en milieu solide qui est intéressante en raison de ses faibles besoins en énergie et de ses faibles rejets d'effluents. Cette technologie pourrait s'appliquer pour traiter le marc de pommes, les déchets d'ananas, les déchets industriels de pommes de terre et de nombreux résidus agro-industriels. La technologie a été d'abord développée au Japon pour fournir un moyen de valoriser les résidus agro-industriels[15]. La moisissure A. niger est cultivée sur un substrat solide dans un environnement à faible activité de l'eau.
L'acide gluconique est un constituant naturel des jus de fruit qui est largement utilisé dans les médicaments, la nourriture, les détergents, le textile, le cuir, etc. Il est autorisé en Europe sous l'étiquette de « E574 » comme additif alimentaire. Il est produit à partir du glucose par une réaction de déshydrogénation catalysée par la glucose oxydase. L'oxydation du groupe aldéhyde en C1 du glucose donne le groupe carboxyle de l'acide. Bien que la conversion puisse être faite par un processus purement chimique, elle est réalisée le plus souvent par fermentation en submersion de Aspergillus niger[17]. Par cette méthode, pratiquement 100 % du glucose est converti en acide gluconique. Dans cette fermentation, A. niger intervient uniquement par la production des enzymes nécessaires à la conversion du glucose en acide gluconique, comme la glucose oxydase, la catalase, la lactonase et la mutarotase. Le gène codant la glucose oxydase de A. niger a été cloné et son amplification se traduit par une augmentation de deux à trois fois de son activité.
Aspergillus niger est un producteur efficace d'acide oxalique[18] grâce à l'oxaloacétate acétylhydrolase (OAH), une enzyme dépendante de Mn2+. Sur le schéma de la section précédente, cette enzyme catalyse la réaction :
- oxaloacétate + H2O → oxalate + acétate.
Mais l'acétate ne s'accumule jamais dans le milieu de culture. Le paramètre externe de contrôle de la production d'acide oxalique semble être le pH.
Production d'enzymes
Pendant des millénaires, les moisissures Aspergillus ont été utilisées en Asie dans divers procédés artisanaux de fermentations naturelles des aliments, sans qu'on connaisse exactement leur fonction exacte. Dans la foulée des travaux de Pasteur et de Emil Hansen sur le rôle des micro-organismes dans la fermentation, il fut établi qu'un des agents causal de ces procédés était les enzymes produites par les champignons filamenteux comme les Aspergillus.
À la fin du XIXe siècle, Herman Ahlburg identifie une moisissure du koji (qui sera nommée plus tard Aspergillus oryzae) puis Takamine Jōkichi isole une enzyme produite par cette moisissure. C'était une amylase qui fut nommée en son honneur takadiastase. Takamine fut le premier dans les années 1891-1894, à réaliser que ces enzymes pouvaient être produites en grande quantité, grâce à la culture de Aspergillus oryzae sur du son de blé. En 1914, il mit au point des bioréacteurs à plateaux puis les bioréacteurs à tambour, pour produire industriellement de l'amylase par cette méthode[19].
Actuellement, Aspergillus niger est cultivé en bioréacteurs pour la production commerciale de nombreuses enzymes utilisées en boulangerie, vinification, brassage[20]. Cette moisissure excrète une vingtaine d'enzymes différentes. Pour une production industrielle, de nombreuses études expérimentales sont nécessaires pour sélectionner une souche productive et déterminer les paramètres physicochimiques optimum (température, pH, oxygénation du milieu etc.) pour un substrat donné (composition du milieu de culture en carbone, azote, phosphate et sels minéraux). En fin de production, les enzymes sont généralement extraites du milieu par centrifugation et précipitation sélectives ; les cellules fongiques séparées peuvent être recyclées comme fertilisant.
La glucose oxydase, la catalase et les hydrolases (cellulase, xylanase, pectinase) sont les principales enzymes utilisées dans la production des bières et des boissons sucrées. La glucose oxydase (EC 1.1.3.4) est une enzyme (qui catalyse l'oxydation du glucose) servant à améliorer la stabilité et la durée de vie des ingrédients. Elle est utilisée conjointement avec la catalase (qui décompose le peroxyde d'hydrogène en eau) comme conservateur du jus d'orange, de la bière et du vin. La glucose oxydase est aussi un améliorant en boulangerie ; ajoutée à la pâte, elle en augmente la consistance et diminue le collant. A. niger est une source importante de ces divers additifs alimentaires enzymatiques[21].
Le Codex Alimentarius[22] de la FAO indique dans sa liste des préparations d'origine microbienne que Aspergillus niger est à l'origine des additifs alimentaires suivants : α-amylase, α-galactosidase, arabino-furanosidase, β-glucanase, catalase, cellobiase, endo-β-gluconase, exo-α-glucosidase, gluco-amylase, glucose oxydase, hemicellulase, inulase, invertase, lactase, lipase, maltase, pectinase, pectine esterase, polygalacturonase, protease, tannase, xylanase
A. niger joue un rôle important dans la biodégradation des produits chimiques les plus toxiques comme l'hexadécane, le traitement des rejets de mélasse des betteraves et des margarines et la bioconversion des boues d'eaux usées
Production de protéines hétérologues
Depuis les années 1990, de nombreuses études ont exploré la possibilité de faire produire des protéines par des champignons filamenteux ne possédant pas le gène codant natif. Les progrès du génie génétique permettent maintenant d'introduire un gène étranger à l'espèce codant une protéine dite hétérologue, comme la chymosine, la phytase et l'aspartyl protéase.
En 1988, une entreprise danoise, Novozymes A/S, fut la première à mettre sur le marché une lipase produite par une souche de Aspergillus oryzae génétiquement modifiée[23]. Les enzymes fongiques hétérologues sont principalement utilisées par l'industrie des détergents. En 2004, peu nombreuses étaient celles à être approuvées pour l'industrie agro-alimentaire. On peut citer parmi les hétérologues produites par A. niger : l'arabinofuranosidase, la catalase, la glucoamylase, la glucose oxydase et la xylase[24]. La difficulté majeure rencontrée avec la production de protéines hétérologues est la faible productivité : ainsi la fermentation d'A. niger produit seulement quelques milligrammes par litre de protéines hétérologues (1,0 mg/l de lysozyme) alors qu'elle peut produire des dizaines de grammes par litre de ses enzymes homologues.
Pathogénicité

Certaines souches de A. niger pourraient produire des ochratoxines A[26]. Dans certains cas, surtout chez les patients immunodéficients, A. niger peut engendrer une otite externe invasive dont les conséquences peuvent aller de la perte définitive de l'audition au décès du patient[27].
Chez les plantes : les oignons entreposés sont sujets à la pourriture du collet causée par Botrytis et à la moisissure noire causée par A. niger. Cette dernière qui est souvent associée aux meurtrissures attaque de même les bulbes d’échalote ou d'ail. La très particulière Welwitschia mirabilis, plante unique en son genre, endémique du désert du Namib, voit un nombre grandissant de plants infectés par A. niger var phoenicis, ce qui pourrait affecter sa capacité de reproduction et la mettre en danger[28].
Notes
- comme gélose de malt, Sabouraud (peptose, glucose, agar), PDA (pomme de terre, dextrose, agar), ou milieu de Czapek (saccharose, sels, agar)
Références
- Mycota
- compendium sur les moisissures
- (en) John I. Pitt et Ailsa D. Hocking, Fungi and Food Spoilage, New York, Springer, , 519 p. (ISBN 978-0-387-92207-2, BNF 44644470, présentation en ligne).
- J. E. Smith, « The Production of Conidiophores and Conidia by Newly Germinated Conidia of Aspergillus niger (Microcycle Conidiation) », Journal of General Microbiology, vol. 69, no 2, , p. 185–197 (ISSN 1350-0872 et 1465-2080, PMID 5146836, DOI 10.1099/00221287-69-2-185, lire en ligne, consulté le )
- Nicolas Quatresous, Aspergillose humaine Épidémiologie, diagnostic biologique, contrôle, Thèse, Université de Limoges,
- Stephen A. Osmani, The Aspergilli : Genomics, Medical Aspects, Biotechnology, and Research Methods, CRC Press, (ISBN 978-1-4200-0851-7).
- Herman J. Pel, « Genome sequencing and analysis of the versatile cell factory Aspergillus niger CBS 513.88 », Nature Biotechnology, vol. 25, no 2, , p. 221–231 (ISSN 1087-0156, DOI 10.1038/nbt1282, lire en ligne, consulté le )
- F Alvarez-Vasquez, C González-Alcón et N V Torres, « Metabolism of citric acid production by Aspergillus niger: model definition, steady-state analysis and constrained optimization of citric acid production rate », Biotechnology and bioengineering, vol. 70, no 1, , p. 82–108 (ISSN 0006-3592, PMID 10940866)
- Mikael Rordam Andersen, Michael Lynge Nielsen et Jens Nielsen, « Metabolic model integration of the bibliome, genome, metabolome and reactome of Aspergillus niger », Molecular Systems Biology, vol. 4, , p. 178 (ISSN 1744-4292, PMID 18364712, PMCID PMC2290933, DOI 10.1038/msb.2008.12, lire en ligne, consulté le )
- Jibin Sun, Xin Lu, Ursula Rinas et An Ping Zeng, « Metabolic peculiarities of Aspergillus niger disclosed by comparative metabolic genomics », Genome biology, vol. 8, no 9, , –182 (ISSN 1465-6914, PMID 17784953, PMCID PMC2375020, DOI 10.1186/gb-2007-8-9-r182)
- Xu-Cong Lv, Xing Weng, Wen Zhang, Ping-Fan Rao et Li Ni, « Microbial diversity of traditional fermentation starters for Hong Qu glutinous rice wine as determined by PCR-mediated DGGE », Food Control, vol. 28, no 2, , p. 426-434 (ISSN 0956-7135, DOI 10.1016/j.foodcont.2012.05.025, lire en ligne, consulté le )
- Michiharu Abe, Naohiro Takaoka, Yoshito Idemoto, Chihiro Takagi, Takuji Imai et Kiyohiko Nakasaki, « Characteristic fungi observed in the fermentation process for Puer tea », International journal of food microbiology, vol. 124, no 2, , p. 199–203 (ISSN 0168-1605, PMID 18455823, DOI 10.1016/j.ijfoodmicro.2008.03.008)
- Maria Papagianni, « Advances in citric acid fermentation by Aspergillus niger: Biochemical aspects, membrane transport and modeling », Biotechnology Advances, vol. 25, no 3, , p. 244–263 (ISSN 0734-9750, DOI 10.1016/j.biotechadv.2007.01.002, lire en ligne, consulté le )
- Carlos R. Soccol, Luciana P. S. Vandenberghe, Cristine Rodrigues and Ashok Pandey, « New Perspectives for Citric Acid Production and Application », Food Technol. Biotechnol., vol. 44, no 2,
- Belén Max, José Manuel Salgado, Noelia Rodríguez, Sandra Cortés, Attilio Converti et José Manuel Domínguez, « Biotechnological production of citric acid », Brazilian Journal of Microbiology, vol. 41, no 4, , p. 862–875 (ISSN 1517-8382, DOI 10.1590/S1517-83822010000400005, lire en ligne, consulté le )
- Sumitra Ramachandran, Pierre Fontanille, Ashok Pandey and Christian Larroche, « Gluconic Acid: Properties, Applications and Microbial Production », Food Technol. Biotechnol., vol. 44, no 2,
- George J. G. Ruijter, Peter J. I. van de Vondervoort et Jaap Visser, « Oxalic acid production by Aspergillus niger: an oxalate-non-producing mutant produces citric acid at pH 5 and in the presence of manganese », Microbiology, vol. 145, no 9, , p. 2569–2576 (ISSN 1350-0872 et 1465-2080, PMID 10517610, lire en ligne, consulté le )
- (en) Hongzhang Chen, Modern solid state fermentation : theory and practice, Dordrecht; New York, Springer, , 324 p. (ISBN 978-94-007-6043-1 et 9400760434, BNF 44722125, présentation en ligne).
- amfep
- Parmjit S Panesar, Satwinder S Marwaha et Harish K Chopra, Enzymes in food processing : fundamentals and potential applications., I K International Publish, 365 p. (ISBN 978-93-80026-33-6 et 9789380026336, présentation en ligne).
- Programme mixte FAO/OMS sur les normes alimentaires, Codex alimentarius : Dispositions générales. Volume 1A, vol. 1A, Rome, Organisation mondiale de la santé, Organisation des Nations Unies pour l'alimentation et l'agriculture, , 397 p. (ISBN 978-92-5-204472-7 et 9789252044727, BNF 37629800, lire en ligne).
- Gustavo H. Goldman et Stephen A. Osmani, The Aspergilli : Genomics, Medical Aspects, Biotechnology, and Research Methods, CRC Press, (ISBN 978-1-4200-0851-7).
- Ruchika Sharma, Meenu Katoch, P. S. Srivastava et G. N. Qazi, « Approaches for refining heterologous protein production in filamentous fungi », World Journal of Microbiology and Biotechnology, vol. 25, no 12, , p. 2083–2094 (ISSN 0959-3993 et 1573-0972, DOI 10.1007/s11274-009-0128-x, lire en ligne, consulté le )
- Hassan Adeyemi Sanuth et Obasola Ezekiel Fagad, « Bio-oxidation of Nylon-6 by Aspergillus niger solated from Solid Waste Dumpsites »,
- Samson RA, Houbraken J, Summerbell RC, Flannigan B, Miller JD (2001). Common and important species of fungi and actinomycetes in indoor environments. In: Microogranisms in Home and Indoor Work Environments. New York: Taylor & Francis. p. 287–292. ISBN.
- (en) P. Parize et al., « Antifungal Therapy of Aspergillus Invasive Otitis Externa: Efficacy of Voriconazole and Review », Antimicrob. Agents Chemother, (DOI 10.1128/AAC.01220-08)
- (en) Herta Kolberg, Christopher Wagner et Gillian A. Cooper-Driver, « Patterns of Aspergillus niger var. phoenicis (Corda) Al-Musallam infection in Namibian populations ofWelwitschia mirabilis Hook.f. », Journal of Arid Environments, vol. 46, no 2, , p. 181–198 (ISSN 0140-1963, lire en ligne [PDF], consulté le )
- Portail de la mycologie


